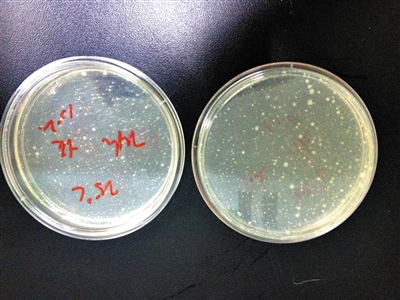

西瓜夏季切开勿放置超4小时 果盘更易滋生细菌
完整小半块西瓜常温放置24小时,同样也是多得难以计算的细菌

西瓜汁在低温冷藏4小时后,菌落“多不可计”
西瓜无疑是夏天最消热解渴的水果。吃西瓜,是一次切小半块拿着啃、分割成小块放到果盘戳着水果签细细品尝、还是榨成西瓜汁直接一饮而尽,哪个更卫生?
6月20日到22日,记者请北京一家专业食品安全一级实验室,在西瓜不同处理方式、不同储存温度下,测试其菌落总数的生长情况,结果发现一些司空见惯的吃瓜方式其实有一定误区,比如我们在餐馆酒店里经常点的西瓜果盘、喝的西瓜汁,更容易滋生细菌。
实验显示,在西瓜最初刚刚被榨成西瓜汁后,马上就滋生了无数多的细菌,菌落总数为“多不可计”,大于30000cfu/g。
喜欢把西瓜分成一个个小块的,尤其是很多餐馆酒楼供应的果盘多数就是分割成小块,无论冷藏还是常温时放置,4个小时内的菌落数量就已是最初的3倍了,6个小时则是最初的3.6倍。
另外,真正到了炎热的高温环境时,无论是完整的半块还是切成小块的西瓜,如果没有任何防护,6个小时内就会长出“多不可计”的细菌。
专家提醒称,“对西瓜的处理方式越复杂,接触的人员、使用的工具越多,与空气接触的时间越长,就越容易给细菌滋生留出空间”。因此尽量别把西瓜榨成汁喝,而切成小块的西瓜也最好在4小时内吃掉。
实验
实验样品:从市场上购买的2个西瓜,每个约7斤左右。
实验时间:6月20日到22日
实验地点:北京一家食品安全一级实验室
实验过程:实验人员首先对西瓜表面进行清洗,消毒刀具、砧板、榨汁机等切瓜要用到的工具,随后把西瓜按照3种方式处理:一部分切成相对完整的小半块,一部分被分割成细碎小块,还有一部分榨成西瓜汁。这些不同形态的西瓜将分别放置在冷藏(0到4℃)、常温(25℃)、高温(37℃)3种不同温度环境中。
同时,实验人员把最初的西瓜样本分别制样,加入培养基,放到恒温培养箱,测出最初的微生物数量。
每隔2个小时,实验人员对不同储存环境的西瓜再次进行上述操作,监测微生物数量的变化情况。
实验结果:(见表格)实验人员介绍,在同样分割处理方式下,每个时间点微生物生长的速率是:低温储藏
实验人员建议,西瓜最好不要榨汁饮用,切开后储存的时间勿超4小时,没吃完的尽量低温冷藏,并尽量保证完整。
另外,由于每个人的体质不一样,对于细菌滋生的西瓜,有人吃了可能不会有明显反应。而一些肠胃功能不好的人吃了可能出现呕吐、腹泻等症状。

